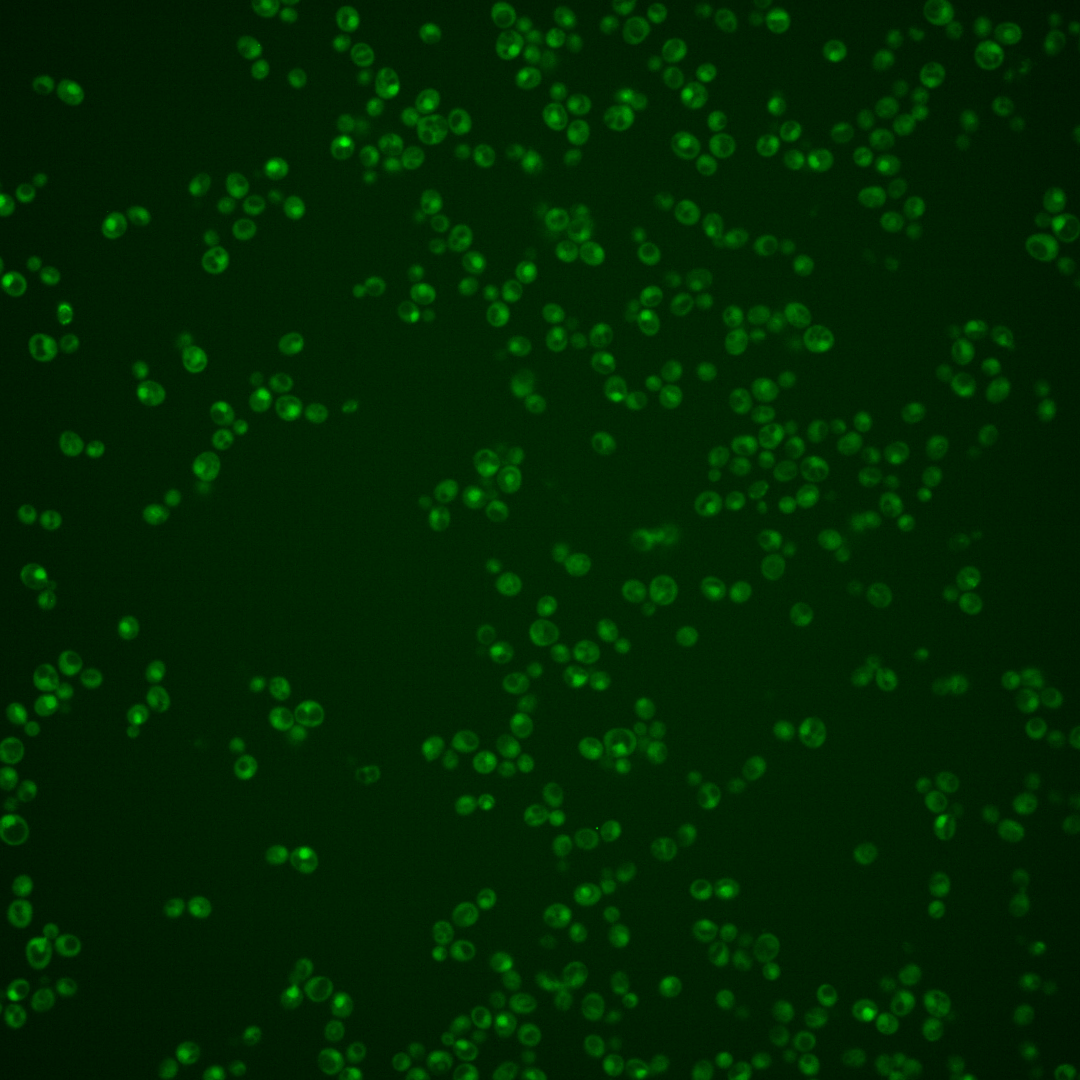
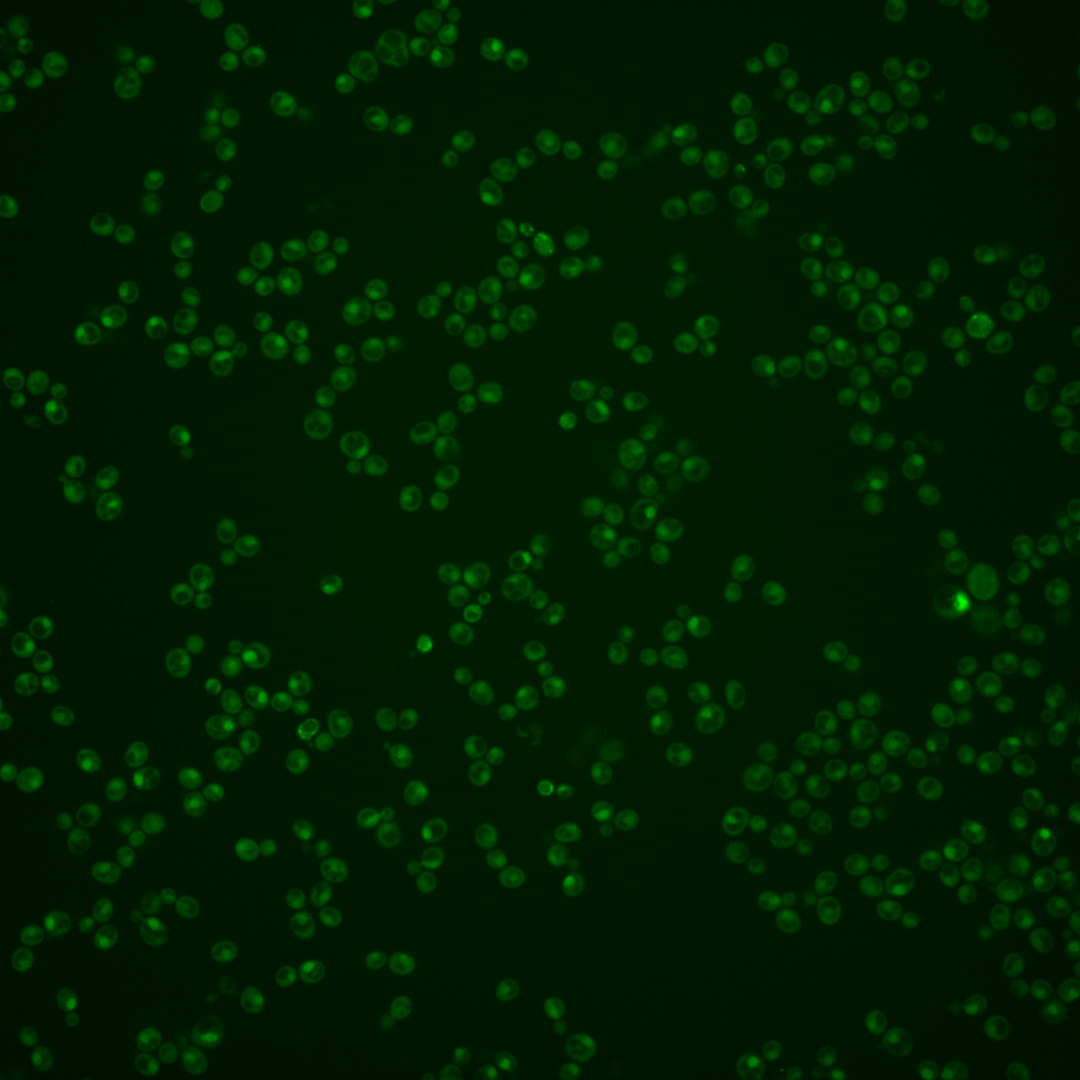
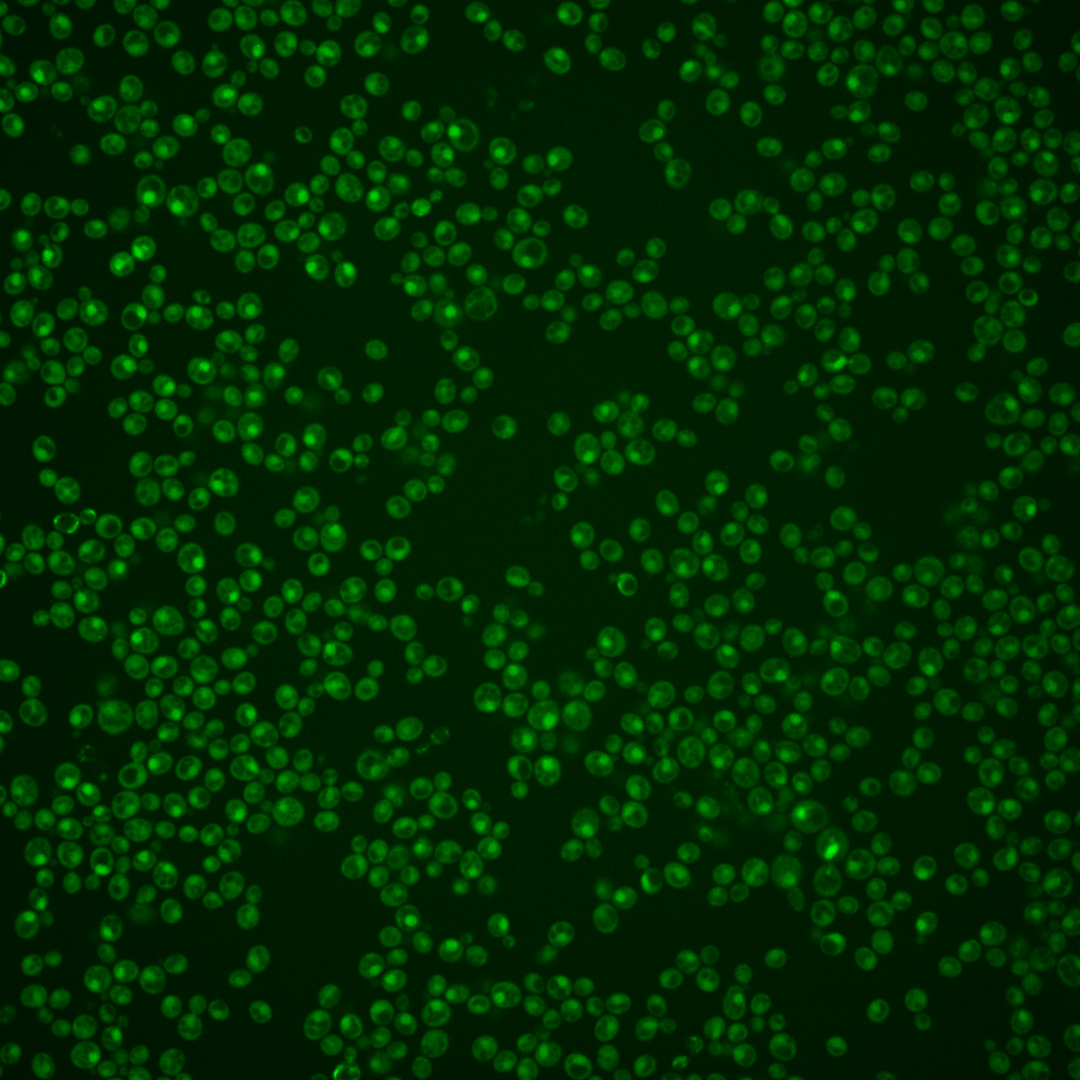
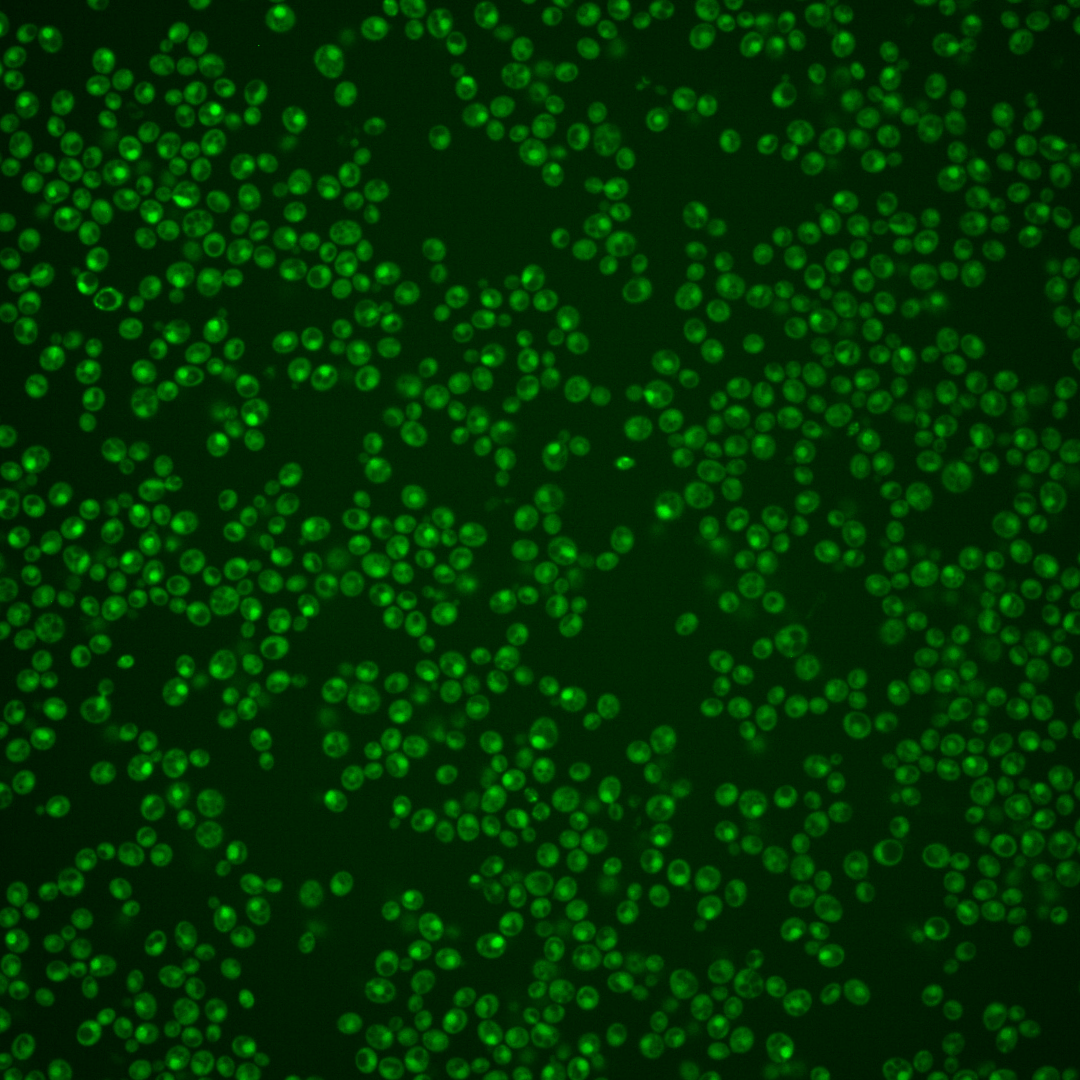
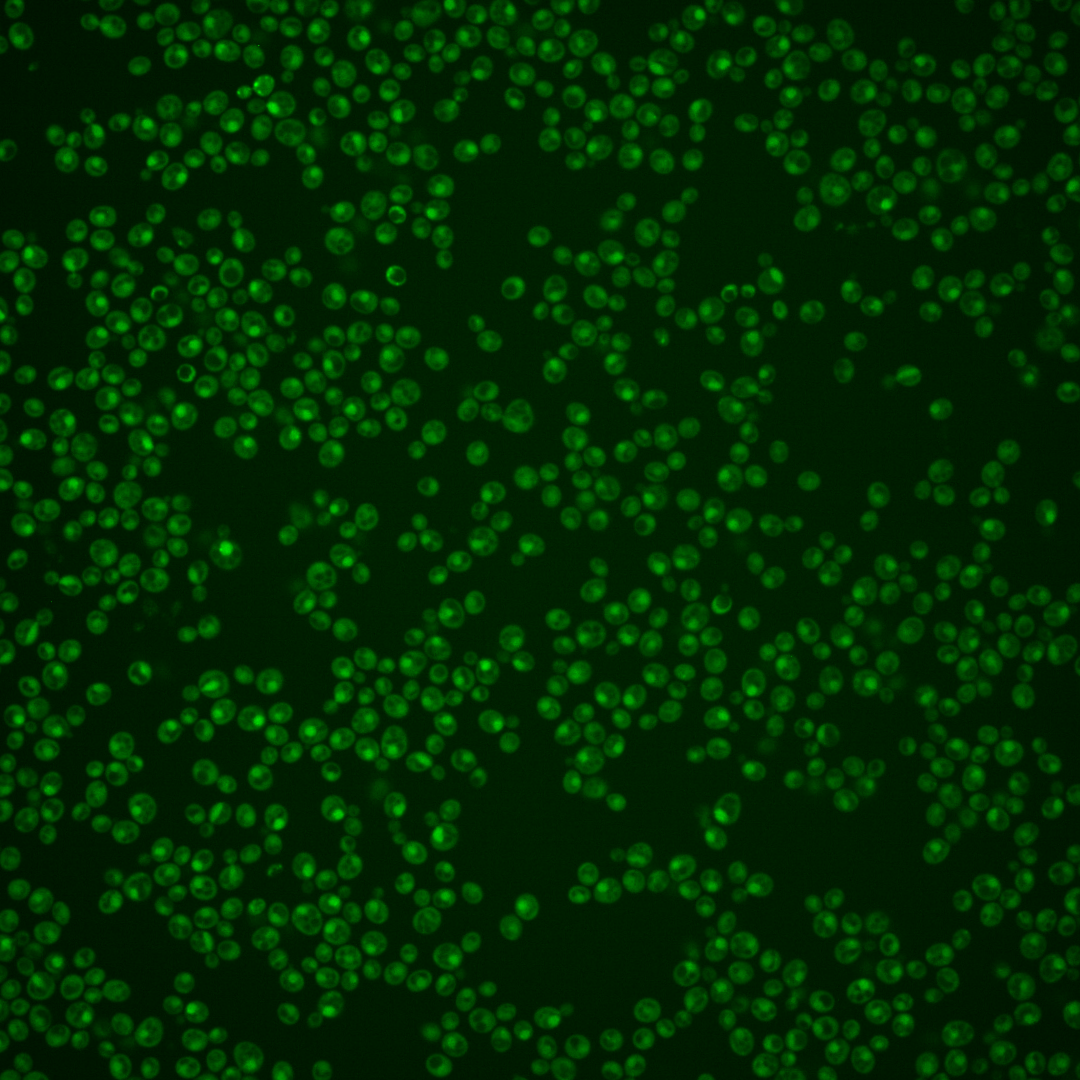

| Standard name | |
|---|---|
| Human Ortholog | |
| Description | Ser/Thr kinase and catalytic subunit of DDK (Dbf4-dependent kinase); required for origin firing and replication initiation; phosphorylates MCM subunits and Cdc45p to drive assembly of the pre-IC and the replicative CMG helicase (Cdc45-MCM-GINS); regulates pre-meiotic DNA replication, meiotic DSB formation, monopolar attachment of homologs during MI by recruiting monopolin to kinetochores, and regulation of middle meiotic genes including NDT80; complemented by co-expression of human CDC7 and DBF4 |
Micrographs




















































































Sub-cellular Localization
Yeast GFP Assignment
Protein Abundance
Localization Change
External localization resources
| ensLOC | DeepLoc | |||||||||||||||||||||||
|---|---|---|---|---|---|---|---|---|---|---|---|---|---|---|---|---|---|---|---|---|---|---|---|---|
| Localization | WT1 | WT2 | WT3 | RAP60 | RAP140 | RAP220 | RAP300 | RAP380 | RAP460 | RAP540 | RAP620 | RAP700 | HU80 | HU120 | HU160 | rpd3Δ_1 | rpd3Δ_2 | rpd3Δ_3 | WT1 | WT2 | WT3 | AF100 | AF140 | AF180 |
| Cortical Patches | 0 | 0 | 0 | 0 | 0 | 0 | 0 | 0 | 0 | 0 | 0 | 0 | 1 | 1 | 0 | 0 | 1 | 0 | 1 | 0 | 1 | 0 | 2 | 5 |
| Bud | 0 | 0 | 1 | 1 | 1 | 2 | 1 | 2 | 5 | 7 | 3 | 2 | 1 | 0 | 0 | 0 | 0 | 1 | 29 | 16 | 9 | 7 | 7 | 7 |
| Bud Neck | 0 | 0 | 0 | 0 | 1 | 0 | 0 | 1 | 0 | 1 | 1 | 0 | 0 | 0 | 0 | 0 | 0 | 0 | 1 | 1 | 1 | 3 | 5 | 12 |
| Bud Site | 0 | 0 | 0 | 1 | 1 | 2 | 0 | 7 | 0 | 2 | 3 | 2 | 0 | 0 | 0 | 0 | 0 | 0 | – | – | – | – | – | – |
| Cell Periphery | 0 | 0 | 0 | 0 | 0 | 0 | 0 | 0 | 1 | 1 | 0 | 2 | 0 | 0 | 1 | 1 | 0 | 0 | 0 | 0 | 0 | 0 | 0 | 0 |
| Cytoplasm | 106 | 79 | 70 | 45 | 47 | 70 | 68 | 81 | 72 | 94 | 62 | 84 | 105 | 157 | 153 | 172 | 114 | 96 | 86 | 53 | 56 | 161 | 188 | 177 |
| Endoplasmic Reticulum | 2 | 0 | 1 | 1 | 2 | 1 | 0 | 0 | 0 | 0 | 0 | 0 | 0 | 2 | 0 | 14 | 16 | 10 | 0 | 1 | 1 | 0 | 5 | 6 |
| Endosome | 1 | 5 | 0 | 0 | 0 | 0 | 2 | 1 | 0 | 0 | 0 | 0 | 3 | 10 | 4 | 8 | 8 | 2 | 6 | 4 | 3 | 7 | 5 | 7 |
| Golgi | 0 | 0 | 0 | 0 | 1 | 0 | 0 | 0 | 0 | 0 | 0 | 0 | 1 | 1 | 0 | 0 | 0 | 0 | 1 | 2 | 0 | 0 | 0 | 2 |
| Mitochondria | 31 | 12 | 25 | 60 | 73 | 89 | 119 | 137 | 151 | 189 | 113 | 157 | 6 | 5 | 11 | 12 | 4 | 4 | 3 | 4 | 5 | 1 | 6 | 6 |
| Nucleus | 93 | 80 | 51 | 75 | 78 | 62 | 58 | 93 | 65 | 77 | 47 | 45 | 133 | 210 | 179 | 146 | 166 | 93 | 126 | 132 | 60 | 43 | 52 | 31 |
| Nuclear Periphery | 1 | 0 | 0 | 0 | 1 | 0 | 0 | 0 | 2 | 1 | 0 | 0 | 0 | 2 | 1 | 0 | 0 | 0 | 1 | 0 | 1 | 0 | 1 | 2 |
| Nucleolus | 2 | 0 | 0 | 0 | 1 | 2 | 1 | 3 | 0 | 1 | 1 | 3 | 0 | 3 | 7 | 2 | 0 | 3 | 2 | 1 | 0 | 1 | 0 | 0 |
| Peroxisomes | 0 | 0 | 0 | 0 | 0 | 0 | 0 | 0 | 0 | 0 | 0 | 0 | 0 | 3 | 1 | 0 | 0 | 0 | 0 | 0 | 0 | 0 | 0 | 0 |
| SpindlePole | 0 | 0 | 0 | 2 | 0 | 0 | 1 | 2 | 0 | 0 | 1 | 1 | 0 | 3 | 1 | 0 | 0 | 0 | 15 | 15 | 10 | 6 | 17 | 13 |
| Vac/Vac Membrane | 81 | 92 | 27 | 11 | 18 | 19 | 14 | 16 | 19 | 20 | 4 | 10 | 84 | 91 | 75 | 138 | 145 | 119 | 24 | 30 | 19 | 21 | 30 | 56 |
| Unique Cell Count | 276 | 239 | 153 | 167 | 183 | 184 | 200 | 252 | 229 | 287 | 172 | 228 | 305 | 446 | 386 | 430 | 379 | 276 | 303 | 270 | 177 | 262 | 332 | 343 |
| Labelled Cell Count | 317 | 268 | 175 | 196 | 224 | 247 | 264 | 343 | 315 | 393 | 235 | 306 | 334 | 488 | 433 | 493 | 454 | 328 | 303 | 270 | 177 | 262 | 332 | 343 |
Yeast GFP Assignment
Protein Abundance
| Screen | WT1 | WT2 | WT3 | RAP60 | RAP140 | RAP220 | RAP300 | RAP380 | RAP460 | RAP540 | RAP620 | RAP700 | HU80 | HU120 | HU160 | rpd3Δ_1 | rpd3Δ_2 | rpd3Δ_3 | AF100 | AF140 | AF180 |
|---|---|---|---|---|---|---|---|---|---|---|---|---|---|---|---|---|---|---|---|---|---|
| Mean Cell GFP Intensity (1e-4) | 5.0 | 5.5 | 4.6 | 4.2 | 4.2 | 3.9 | 3.4 | 3.4 | 3.5 | 3.2 | 3.6 | 3.0 | 6.3 | 6.3 | 6.2 | 6.5 | 8.1 | 8.1 | 5.1 | 5.1 | 6.1 |
| Std Deviation (1e-4) | 0.7 | 0.9 | 1.1 | 1.2 | 1.1 | 1.4 | 1.3 | 0.8 | 1.3 | 1.1 | 1.7 | 1.3 | 1.4 | 1.7 | 1.7 | 1.4 | 1.6 | 1.6 | 1.2 | 1.3 | 1.4 |
| Intensity Change (Log2) | – | – | – | -0.11 | -0.13 | -0.21 | -0.43 | -0.42 | -0.37 | -0.52 | -0.35 | -0.58 | 0.47 | 0.46 | 0.44 | 0.52 | 0.83 | 0.83 | 0.16 | 0.17 | 0.41 |
Localization Change
| Localization | RAP60 | RAP140 | RAP220 | RAP300 | RAP380 | RAP460 | RAP540 | RAP620 | RAP700 | HU80 | HU120 | HU160 | rpd3Δ_1 | rpd3Δ_2 | rpd3Δ_3 |
|---|---|---|---|---|---|---|---|---|---|---|---|---|---|---|---|
| Cortical Patches | 0 | 0 | 0 | 0 | 0 | 0 | 0 | 0 | 0 | 0 | 0 | 0 | 0 | 0 | 0 |
| Bud | 0 | 0 | 0 | 0 | 0 | 0 | 0 | 0 | 0 | 0 | 0 | 0 | 0 | 0 | 0 |
| Bud Neck | 0 | 0 | 0 | 0 | 0 | 0 | 0 | 0 | 0 | 0 | 0 | 0 | 0 | 0 | 0 |
| Bud Site | 0 | 0 | 0 | 0 | 0 | 0 | 0 | 0 | 0 | 0 | 0 | 0 | 0 | 0 | 0 |
| Cell Periphery | 0 | 0 | 0 | 0 | 0 | 0 | 0 | 0 | 0 | 0 | 0 | 0 | 0 | 0 | 0 |
| Cytoplasm | -3.5 | -3.8 | -1.4 | -2.2 | -2.7 | -2.8 | -2.7 | -1.8 | -1.7 | -2.4 | -2.3 | -1.3 | -1.2 | -3.4 | -2.2 |
| Endoplasmic Reticulum | 0 | 0 | 0 | 0 | 0 | 0 | 0 | 0 | 0 | 0 | 0 | 0 | 0 | 0 | 0 |
| Endosome | 0 | 0 | 0 | 0 | 0 | 0 | 0 | 0 | 0 | 0 | 0 | 0 | 0 | 0 | 0 |
| Golgi | 0 | 0 | 0 | 0 | 0 | 0 | 0 | 0 | 0 | 0 | 0 | 0 | 0 | 0 | 0 |
| Mitochondria | 0 | 0 | 0 | 0 | 0 | 0 | 0 | 0 | 0 | -5.8 | -7.4 | -5.7 | -5.9 | -7.0 | -5.9 |
| Nucleus | 2.1 | 1.7 | 0.1 | -0.9 | 0.7 | -1.0 | -1.4 | -1.2 | -3.0 | 2.1 | 3.0 | 2.8 | 0.1 | 2.2 | 0.1 |
| Nuclear Periphery | 0 | 0 | 0 | 0 | 0 | 0 | 0 | 0 | 0 | 0 | 0 | 0 | 0 | 0 | 0 |
| Nucleolus | 0 | 0 | 0 | 0 | 0 | 0 | 0 | 0 | 0 | 0 | 0 | 0 | 0 | 0 | 0 |
| Peroxisomes | 0 | 0 | 0 | 0 | 0 | 0 | 0 | 0 | 0 | 0 | 0 | 0 | 0 | 0 | 0 |
| SpindlePole | 0 | 0 | 0 | 0 | 0 | 0 | 0 | 0 | 0 | 0 | 0 | 0 | 0 | 0 | 0 |
| Vacuole | -3.1 | -2.1 | -1.9 | -3.1 | -3.6 | -2.8 | -3.5 | -4.7 | -4.3 | 2.3 | 0.7 | 0.5 | 3.4 | 4.6 | 5.3 |
External localization resources
Images






























Protein Concentration and Protein Localization Data
| R1 | R2 | R3 | ||||||||||||||||
|---|---|---|---|---|---|---|---|---|---|---|---|---|---|---|---|---|---|---|
| G1 Pre-START | G1 Post-START | S/G2 | Metaphase | Anaphase | Telophase | G1 Pre-START | G1 Post-START | S/G2 | Metaphase | Anaphase | Telophase | G1 Pre-START | G1 Post-START | S/G2 | Metaphase | Anaphase | Telophase | |
| Concentration | 4.5885 | 5.0109 | 5.3095 | 4.8041 | 4.1028 | 5.0649 | 1.9952 | 2.6985 | 2.9127 | 2.4988 | 2.7196 | 2.4742 | 4.1613 | 3.8372 | 3.5361 | 4.2598 | 4.1132 | 3.1836 |
| Actin | 0.0287 | 0.0161 | 0.0253 | 0.0001 | 0.0044 | 0.0028 | 0.0223 | 0.0013 | 0.007 | 0.0007 | 0.0307 | 0.0056 | 0.0878 | 0.0003 | 0.0244 | 0.0353 | 0.0007 | 0.0006 |
| Bud | 0.0015 | 0.0023 | 0.0007 | 0 | 0.0002 | 0.0011 | 0.0014 | 0.0002 | 0.0001 | 0 | 0.0004 | 0.0003 | 0.0024 | 0.0002 | 0.0005 | 0.0015 | 0.0001 | 0.0002 |
| Bud Neck | 0.0024 | 0.0009 | 0.0005 | 0.0002 | 0.004 | 0.0107 | 0.003 | 0.0007 | 0.0009 | 0.0004 | 0.0012 | 0.0038 | 0.027 | 0.0008 | 0.002 | 0.0038 | 0.0027 | 0.0032 |
| Bud Periphery | 0.0016 | 0.002 | 0.0007 | 0 | 0.0002 | 0.0017 | 0.0022 | 0.0001 | 0.0001 | 0.0001 | 0.0004 | 0.0003 | 0.0041 | 0.0001 | 0.0007 | 0.0015 | 0.0001 | 0.0001 |
| Bud Site | 0.0039 | 0.0068 | 0.0095 | 0.0001 | 0.0005 | 0.0007 | 0.0054 | 0.0024 | 0.0017 | 0.0001 | 0.0009 | 0.0004 | 0.0081 | 0.002 | 0.0152 | 0.0108 | 0.001 | 0.0006 |
| Cell Periphery | 0.0003 | 0.0002 | 0.0001 | 0 | 0.0001 | 0.0001 | 0.0004 | 0.0001 | 0 | 0 | 0.0001 | 0.0001 | 0.0009 | 0.0001 | 0.0004 | 0.0001 | 0.0001 | 0 |
| Cytoplasm | 0.2833 | 0.2119 | 0.028 | 0.0138 | 0.164 | 0.2704 | 0.2576 | 0.129 | 0.0279 | 0.0148 | 0.1708 | 0.2356 | 0.3019 | 0.2896 | 0.0516 | 0.0222 | 0.3172 | 0.3543 |
| Cytoplasmic Foci | 0.0262 | 0.0034 | 0.002 | 0.0005 | 0.0128 | 0.0068 | 0.0165 | 0.0034 | 0.0084 | 0.0005 | 0.0133 | 0.0085 | 0.0203 | 0.0029 | 0.001 | 0.0177 | 0.0028 | 0.0075 |
| Eisosomes | 0.0003 | 0.0001 | 0.0001 | 0 | 0.0001 | 0.0001 | 0.0007 | 0 | 0.0002 | 0 | 0.0002 | 0 | 0.0005 | 0 | 0.0004 | 0.0001 | 0 | 0 |
| Endoplasmic Reticulum | 0.0137 | 0.0056 | 0.0016 | 0.0007 | 0.0103 | 0.0054 | 0.0102 | 0.0035 | 0.0013 | 0.0011 | 0.0073 | 0.0038 | 0.0581 | 0.0029 | 0.0008 | 0.0005 | 0.0044 | 0.0044 |
| Endosome | 0.047 | 0.0042 | 0.0054 | 0.001 | 0.0139 | 0.0074 | 0.0211 | 0.005 | 0.0056 | 0.0015 | 0.0189 | 0.0074 | 0.0505 | 0.0009 | 0.001 | 0.0076 | 0.0036 | 0.004 |
| Golgi | 0.0064 | 0.0012 | 0.0025 | 0 | 0.0023 | 0.0016 | 0.0062 | 0.0004 | 0.0021 | 0 | 0.0058 | 0.0008 | 0.0182 | 0.0001 | 0.0006 | 0.0117 | 0.0001 | 0.0011 |
| Lipid Particles | 0.0085 | 0.0005 | 0.0049 | 0 | 0.0056 | 0.0031 | 0.01 | 0.0004 | 0.0017 | 0.0001 | 0.0144 | 0.001 | 0.0318 | 0.0001 | 0.0005 | 0.0021 | 0.0003 | 0.0113 |
| Mitochondria | 0.013 | 0.0022 | 0.0026 | 0.0002 | 0.0009 | 0.0016 | 0.0072 | 0.0007 | 0.0011 | 0.0011 | 0.0024 | 0.0028 | 0.0048 | 0.0003 | 0.0041 | 0.0017 | 0.0006 | 0.0018 |
| None | 0.0903 | 0.0567 | 0.0105 | 0.0035 | 0.0179 | 0.1139 | 0.1937 | 0.0737 | 0.033 | 0.0136 | 0.0896 | 0.1251 | 0.0918 | 0.1377 | 0.006 | 0.1042 | 0.0665 | 0.0557 |
| Nuclear Periphery | 0.0526 | 0.0164 | 0.0102 | 0.0222 | 0.0181 | 0.0132 | 0.0313 | 0.0135 | 0.013 | 0.0301 | 0.0346 | 0.0143 | 0.0463 | 0.0065 | 0.0069 | 0.0038 | 0.0253 | 0.0138 |
| Nucleolus | 0.0043 | 0.004 | 0.0034 | 0.0018 | 0.0032 | 0.0031 | 0.005 | 0.0026 | 0.0034 | 0.0038 | 0.0046 | 0.0041 | 0.0042 | 0.0018 | 0.0024 | 0.001 | 0.0043 | 0.0029 |
| Nucleus | 0.3566 | 0.6479 | 0.8829 | 0.9485 | 0.7198 | 0.5323 | 0.3615 | 0.745 | 0.8748 | 0.924 | 0.561 | 0.5513 | 0.1914 | 0.5399 | 0.8768 | 0.7598 | 0.4745 | 0.4954 |
| Peroxisomes | 0.0171 | 0.0013 | 0.0023 | 0 | 0.001 | 0.0016 | 0.0119 | 0.0003 | 0.0061 | 0.0001 | 0.011 | 0.0027 | 0.0114 | 0.0001 | 0.0014 | 0.0121 | 0.0001 | 0.0021 |
| Punctate Nuclear | 0.0278 | 0.0101 | 0.0054 | 0.0068 | 0.0176 | 0.0181 | 0.0213 | 0.015 | 0.0103 | 0.0074 | 0.0275 | 0.0285 | 0.025 | 0.0117 | 0.0022 | 0.002 | 0.0929 | 0.0392 |
| Vacuole | 0.0108 | 0.0057 | 0.0013 | 0.0003 | 0.0026 | 0.0034 | 0.0088 | 0.0024 | 0.0009 | 0.0004 | 0.0039 | 0.0031 | 0.0106 | 0.0017 | 0.0009 | 0.0004 | 0.0022 | 0.0016 |
| Vacuole Periphery | 0.0036 | 0.0006 | 0.0003 | 0.0002 | 0.0005 | 0.0009 | 0.0023 | 0.0003 | 0.0003 | 0.0004 | 0.0012 | 0.0005 | 0.003 | 0.0002 | 0.0002 | 0.0001 | 0.0005 | 0.0003 |
Sequencing Data
| R1 | R2 | |||||||||
|---|---|---|---|---|---|---|---|---|---|---|
| G1 Post-START | S/G2 | Metaphase | Anaphase | Telophase | G1 Post-START | S/G2 | Metaphase | Anaphase | Telophase | |
| Gene Expression | 11.2223 | 11.0029 | 8.1646 | 8.7163 | 7.0404 | 5.0653 | 6.5441 | 6.6253 | 7.0319 | 10.8934 |
| Translational Efficiency | 1.0654 | 0.8436 | 0.8764 | 1.0704 | 1.3681 | 2.5106 | 1.3834 | 1.2891 | 1.27 | 1.0746 |
Hit Data
| Dataset | Hit |
|---|---|
| Protein Concentration | ✘ |
| Protein Localization | ✔ |
| Gene Expression | ✘ |
| Translational Efficiency | ✘ |
Endocytosis
| Temp | Actin Patch (Sac6-tdTomato) | Cortical Patch (Sla1-GFP) | Late Endosome (Snf7-GFP) | Vacuole (Vph1-GFP) |
|---|---|---|---|---|
| 37℃ | ||||
| RT |
Cell Cycle Omics
CYCLoPs (Cdc7-GFP)
| Gene / Allele | Actin Patch (Sac6-tdTomato) | Cortical Patch (Sla1-GFP) | Late Endosome (Snf7-GFP) | Vacuole (Sac6-tdTomato) |
|---|
| Gene | Images |
|---|
| Gene | Images |
|---|
Images are not yet available
Images are not yet available